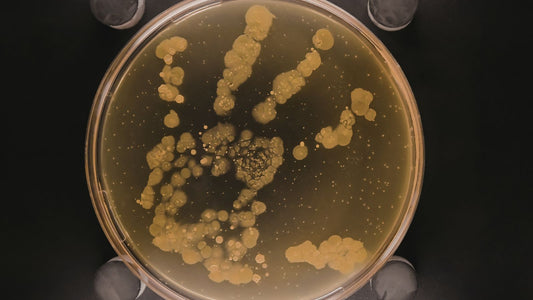
The Skin Microbiome: What It Is, Why It Matters, and How to Protect It

Your Body Systems

Estrogen and Skin: How the Hormone That Defines...
No hormone has a more comprehensive influence on skin health in women than estrogen. It regulates collagen synthesis and degradation, barrier lipid production, sebaceous gland activity, melanocyte behavior, wound healing...
Estrogen and Skin: How the Hormone That Defines...
No hormone has a more comprehensive influence on skin health in women than estrogen. It regulates collagen synthesis and degradation, barrier lipid production, sebaceous gland activity, melanocyte behavior, wound healing...

What Is the Endocrine System? Hormones, Glands,...
Your skin does not operate in isolation. It is in constant communication with your body's hormonal system — receiving signals that regulate how much oil it produces, how quickly it...
What Is the Endocrine System? Hormones, Glands,...
Your skin does not operate in isolation. It is in constant communication with your body's hormonal system — receiving signals that regulate how much oil it produces, how quickly it...
The Skin Microbiome: What It Is, Why It Matters...
Your skin is not sterile. It is home to a complex, dynamic community of microorganisms — bacteria, fungi, viruses, and mites — that have co-evolved with the human body over...
The Skin Microbiome: What It Is, Why It Matters...
Your skin is not sterile. It is home to a complex, dynamic community of microorganisms — bacteria, fungi, viruses, and mites — that have co-evolved with the human body over...

Collagen and Elastin: What They Are, How They W...
If skin is a building, collagen and elastin are the architecture. Collagen provides the load-bearing framework — the tensile strength that keeps skin firm and resistant to deformation. Elastin provides...
Collagen and Elastin: What They Are, How They W...
If skin is a building, collagen and elastin are the architecture. Collagen provides the load-bearing framework — the tensile strength that keeps skin firm and resistant to deformation. Elastin provides...

The Skin Barrier: What It Is, How It Works, and...
The skin barrier is one of the most talked-about concepts in modern skincare — and one of the least accurately explained. It is not a film you apply. It is...
The Skin Barrier: What It Is, How It Works, and...
The skin barrier is one of the most talked-about concepts in modern skincare — and one of the least accurately explained. It is not a film you apply. It is...

What Is Skin? A Complete Guide to How Your Skin...
Your skin does a lot for you. It keeps infections out, regulates your body temperature, synthesizes vitamins, processes sensory information, and acts as the first line of defense against a...
What Is Skin? A Complete Guide to How Your Skin...
Your skin does a lot for you. It keeps infections out, regulates your body temperature, synthesizes vitamins, processes sensory information, and acts as the first line of defense against a...
